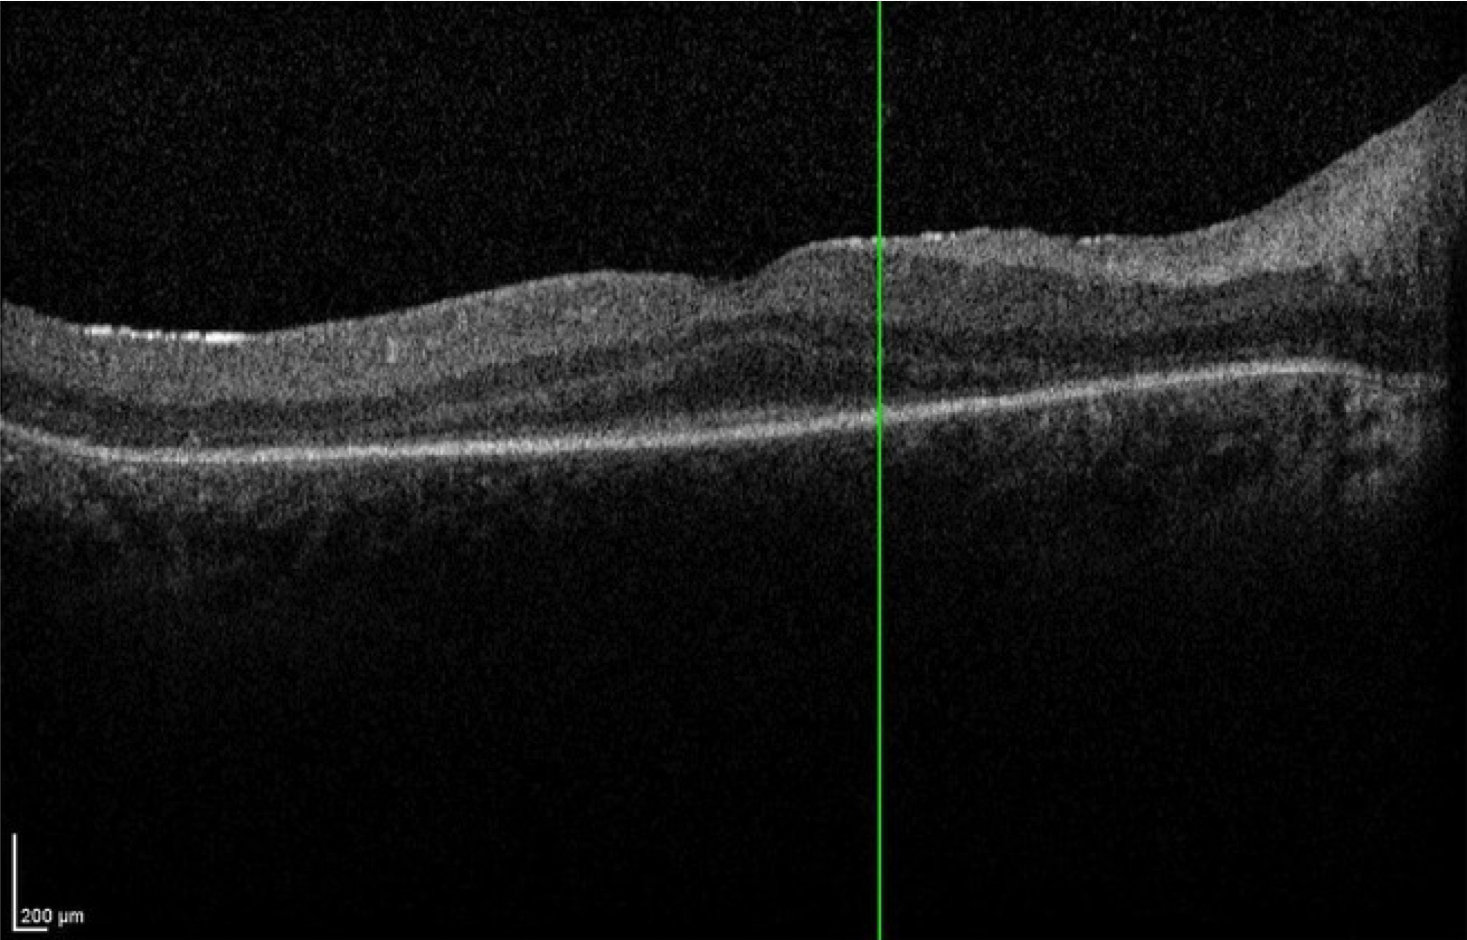

Big 14 Self-Assessment
Case 13
Case 13 is a 15 year old male was noted to have abnormal vision at 3 months of age. He had large amplitude nystagmus, did not respond to his parents faces and would not follow any type of toy or light that was put in front of him. His pupils constricted when the room lights were turned off and dilated when they were turned on. Retinoscopy revealed over seven diopters of hyperopia and electroretinography detected no responses under any stimulus conditions. The best acuity ever recorded has been bare light perception. His parents have normal vision.